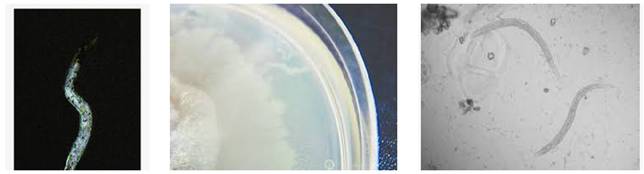

Ký sinh trùng giun lươn là một trong những bệnh ký sinh trùng cơ hội trên các bệnh nhân có bệnh lý nền, hệ thống miễn dịch suy yếu như nhiễm trùng HIV/AIDS, đái tháo đường, bệnh hệ thống, hội chứng chuyển hóa, lao phổi, ung thư, các bệnh nhân đang dùng thuốc chống ung thư, các bệnh nhân viêm khớp mạn tính, cần sử dụng thuốc corticoides dài ngày, các bệnh lý viêm đa khớp mạn tính,…đều có cơ hội cao cho nhiếm ấu trùng giun lươn Strongyloides stercoralis.
Đặc biệt trên các cơ địa đó, chúng thường gây ra hội chứng tăng nhiễm dẫn đến bệnh nhân thường mắc các biến chứng nặng hơn và dễ dẫn đến tử vong cao. Nhân đây, chúng tôi xin cập nhật một số nghiên cứu liên quan đến nhiễm trùng loài ký sinh trùng này với các yếu tố nguy cơ cao dễ dẫn đến nhiễm.
Strongyloidiasis--the most neglected of the neglected tropical diseases?
Olsen A, van Lieshout L, Marti H, Polderman T, Polman K, Steinmann P, Stothard R, Thybo S, Verweij JJ, Magnussen P.Trans R Soc Trop Med Hyg. 2009 Oct;103(10):967-72. doi: 10.1016/j.trstmh.2009.02.013. Epub 2009 Mar 27. Review.PMID: 19328508 Similar articlesSelect item 828458912.
[The importance of Strongyloides stercoralis revisited].
Pires ML, Dreyer G.Rev Hosp Clin Fac Med Sao Paulo. 1993 Jul-Aug;48(4):175-82. Review. Portuguese. PMID: 8284589 Similar articlesSelect item 919567713.
Pulmonary manifestations of strongyloidiasis.
Wehner JH, Kirsch CM.Semin Respir Infect. 1997 Jun;12(2):122-9. Review.PMID: 9195677 Similar articlesSelect item 756963814.
Serodiagnosis of strongyloidiasis. The application and significance.
Sato Y, Kobayashi J, Shiroma Y.Rev Inst Med Trop Sao Paulo. 1995 Jan-Feb;37(1):35-41. Review.PMID: 7569638 Similar articles Select item 1632147015.
Parasitological and serological diagnosis of Strongyloides stercoralis in domesticated dogs from southeastern Brazil.
Júnior AF, Gonçalves-Pires MR, Silva DA, Gonçalves AL, Costa-Cruz JM.Vet Parasitol. 2006 Mar 15;136(2):137-45.PMID: 16321470 Similar articles Select item 888052116.
Patterns of detection of Strongyloides stercoralis in stool specimens: implications for diagnosis and clinical trials.
Dreyer G, Fernandes-Silva E, Alves S, Rocha A, Albuquerque R, Addiss D.J Clin Microbiol. 1996 Oct;34(10):2569-71.PMID: 8880521 Free PMC Article Similar articles Select item 1040332917.
Fluctuations of larval excretion in Strongyloides stercoralis infection.
Uparanukraw P, Phongsri S, Morakote N.Am J Trop Med Hyg. 1999 Jun;60(6):967-73.PMID: 10403329 Similar articles Select item 1717691918.
Minimal change nephrotic syndrome in association with strongyloidiasis.
Hsieh YP, Wen YK, Chen ML.Clin Nephrol. 2006 Dec;66(6):459-63.PMID: 17176919 Similar articles Select item 2378376019.
Strongyloides stercoralis, the hidden worm. Epidemiological and clinical characteristics of 70 cases diagnosed in the North Metropolitan Area of Barcelona, Spain, 2003-2012.
Valerio L, Roure S, Fernández-Rivas G, Basile L, Martínez-Cuevas O, Ballesteros ÁL, Ramos X, Sabrià M; North Metropolitan Working Group on Imported Diseases.Trans R Soc Trop Med Hyg. 2013 Aug;107(8):465-70. doi: 10.1093/trstmh/trt053. Epub 2013 Jun 19.PMID: 23783760 Similar articlesSelect item 1550037620.
Treatment strategies in controlling strongyloidiasis.
Satoh M, Kokaze A.Expert Opin Pharmacother. 2004 Nov;5(11):2293-301. Review.PMID: 15500376 Similar articles
Evaluation of techniques for the diagnosis of Strongyloides stercoralis in human immunodeficiency virus (HIV) positive and HIV negative individuals in the city of Itajaí, Brazil.
Marchi Blatt J, Cantos GA.Braz J Infect Dis. 2003 Dec;7(6):402-8.PMID: 14636480 Free Article Similar articles Select item 2165410922.
Risk factors for acquiring Strongyloides stercoralis infection among patients attending a tertiary hospital in south India.
Chordia P, Christopher S, Abraham OC, Muliyil J, Kang G, Ajjampur Ss.Indian J Med Microbiol. 2011 Apr-Jun;29(2):147-51. doi: 10.4103/0255-0857.81797.PMID: 21654109 Free Article Similar articles Select item 1059293723.
Hemodialysis and strongyloidiasis: a presumed cause of eosinophilia able to mask the other.
Saïd S, Nevez G, Morinière P, Fournier A, Raccurt CP.Nephrologie. 1999;20(6):343-6. French. PMID: 10592937 Similar articles Select item 942821124.
Image of the month. Strongyloides stercoralis larvae.
Hokama A, Adaniya H, Saito A.Gastroenterology. 1998 Jan;114(1):6, 230. No abstract available. PMID: 9428211 Similar articles Select item 1289410925.
Cutaneous Strongyloides stercoralis infection: an unusual presentation.
Ly MN, Bethel SL, Usmani AS, Lambert DR.J Am Acad Dermatol. 2003 Aug;49(2 Suppl Case Reports):S157-60.PMID: 12894109 Similar articles Select item 1261123626.
[Immunodiagnosis of Strongyloides stercoralis infections in Chile using ELISA test].
Mercado R, Jercic MI, Torres P, Alcayaga S, Martins de Paula F, Costa-Cruz JM, Ueta MT.Rev Med Chil. 2002 Dec;130(12):1358-64. Spanish. PMID: 12611236 Similar articlesSelect item 1195011727.
Clinical manifestations of strongyloidiasis in southern Taiwan.
Tsai HC, Lee SS, Liu YC, Lin WR, Huang CK, Chen YS, Wann SR, Tsai TH, Lin HH, Yen MY, Yen CM, Chen ER.J Microbiol Immunol Infect. 2002 Mar;35(1):29-36.PMID: 11950117 Similar articles Select item 1222458528.
Serology and eosinophil count in the diagnosis and management of strongyloidiasis in a non-endemic area.
Loutfy MR, Wilson M, Keystone JS, Kain KC.Am J Trop Med Hyg. 2002 Jun;66(6):749-52.PMID: 12224585 Similar articlesSelect item 672390029.
Strongyloides stercoralis: hyperinfection in immunosuppressed dogs.
Schad GA, Hellman ME, Muncey DW.Exp Parasitol. 1984 Jun;57(3):287-96.PMID: 6723900 Similar articlesSelect item 2073348130.
Strongyloides stercoralis: there but not seen.
Montes M, Sawhney C, Barros N.Curr Opin Infect Dis. 2010 Oct;23(5):500-4. doi: 10.1097/QCO.0b013e32833df718. Review.PMID: 20733481 Free PMC Article Similar articles. Select item 2160277031.
Strongyloides stercoralis induced bilateral blood stained pleural effusion in patient with recurrent Non-Hodgkin lymphoma.
Win TT, Sitiasma H, Zeehaida M.Trop Biomed. 2011 Apr;28(1):64-7.PMID: 21602770 Free Article Similar articles Select item 873124132.

Hình 1
Reactive arthritis induced by Strongyloides stercoralis.
Brocq O, Breuil V, Agopian V, Grisot C, Flory P, Bernard-Pomier G, Ziegler G, Euller-Ziegler L.Rev Rhum Engl Ed. 1996 Mar;63(3):217-9. Review.PMID: 8731241 Similar articlesSelect item 722777233.
Clinical features of Strongyloides stercoralis infection in an endemic area of the United States.
Milder JE, Walzer PD, Kilgore G, Rutherford I, Klein M.Gastroenterology. 1981 Jun;80(6):1481-8.PMID: 7227772 Similar articles Select item 1271533334.
Hyperinfection syndrome in strongyloidiasis: report of two cases.
Lemos LB, Qu Z, Laucirica R, Fred HL.Ann Diagn Pathol. 2003 Apr;7(2):87-94.PMID: 12715333 Similar articles Select item 1625887335.
Fatal outcome of a hyperinfection syndrome despite successful eradication of Strongyloides with subcutaneous ivermectin.
Hauber HP, Galle J, Chiodini PL, Rupp J, Birke R, Vollmer E, Zabel P, Lange C.Infection. 2005 Oct;33(5-6):383-6.PMID: 16258873 Similar articlesSelect item 1060410336.
Mistaken diagnosis of eosinophilic colitis.
Corsetti M, Basilisco G, Pometta R, Allocca M, Conte D.Ital J Gastroenterol Hepatol. 1999 Oct;31(7):607-9.PMID: 10604103 Similar articlesSelect item 2106194237.
Effective diagnostic tests and anthelmintic treatment for Strongyloides stercoralis make community control feasible.
Shield JM, Page W.P N G Med J. 2008 Sep-Dec;51(3-4):105-19.PMID: 21061942 Similar articlesSelect item 1914409538.
Strongyloides stercoralis hyperinfection in hematopoietic stem cell transplantation.
Wirk B, Wingard JR.Transpl Infect Dis. 2009 Apr;11(2):143-8. doi: 10.1111/j.1399-3062.2008.00360.x. Epub 2008 Dec 17.PMID: 19144095 Similar articlesSelect item 1222427039.
[A case of severe strongyloidiasis].
Tumol'skaia NI, Mazmanian MV, Pliushcheva GL, Rogova LA.Med Parazitol (Mosk). 2002 Jan-Mar;(1):50-2. Russian. No abstract available. PMID: 12224270 Similar articlesSelect item 951315440.
[Aseptic purulent meningitis in two patients co-infected by HTLV-1 and Strongyloides stercoralis].
Foucan L, Genevier I, Lamaury I, Strobel M.Med Trop (Mars). 1997;57(3):262-4. French. PMID: 9513154 Similar articles
Fatal Strongyloides stercoralis infection in a patient with chronic inflammatory demyelinating polyneuropathy.
Kalita J, Bhoi SK, Misra UK.Pathog Glob Health. 2012 Aug;106(4):249-51. doi: 10.1179/2047773212Y.0000000030.PMID: 23265427 Free PMC Article Similar articles Select item 1577168442.
Epidemiological and clinical interaction between HTLV-1 and Strongyloides stercoralis.
Carvalho EM, Da Fonseca Porto A.Parasite Immunol. 2004 Nov-Dec;26(11-12):487-97. Review.PMID: 15771684 Free Article Similar articles Select item 1286909443.
Clinical presentation and diagnostic sensitivity of laboratory tests for Strongyloides stercoralis in travellers compared with immigrants in a non-endemic country.
Sudarshi S, Stümpfle R, Armstrong M, Ellman T, Parton S, Krishnan P, Chiodini PL, Whitty CJ.Trop Med Int Health. 2003 Aug;8(8):728-32.PMID: 12869094 Free Article Similar articles Select item 1656992444.
Strongyloides stercoralis infestation in a patient with severe ulcerative colitis.
Ghoshal UC, Alexender G, Ghoshal U, Tripathi S, Krishnani N.Indian J Med Sci. 2006 Mar;60(3):106-10.PMID: 16569924 Similar articles Select item 2947435645.
Management of severe strongyloidiasis attended at reference centers in Spain.
Martinez-Perez A, Roure Díez S, Belhassen-Garcia M, Torrús-Tendero D, Perez-Arellano JL, Cabezas T, Soler C, Díaz-Menéndez M, Navarro M, Treviño B, Salvador F; Soil-Transmitted Helminths’ Study Group of the Spanish Society of Tropical Medicine and International Health (SEMTSI).PLoS Negl Trop Dis. 2018 Feb 23;12(2):e0006272. doi: 10.1371/journal.pntd.0006272. eCollection 2018 Feb.PMID: 29474356 Free PMC Article Similar articles Select item 1797807146.
Increased detection rate of Strongyloides stercoralis by repeated stool examinations using the agar plate culture method.
Hirata T, Nakamura H, Kinjo N, Hokama A, Kinjo F, Yamane N, Fujita J.Am J Trop Med Hyg. 2007 Oct;77(4):683-4.PMID: 17978071 Similar articles Select item 1736854947.
Dissemination: the fatal risk for a missed diagnosis of Strongyloides stercoralis infection.
Boscolo M, Bisoffi Z.J Infect. 2007 Sep;55(3):284-5. Epub 2007 Mar 26. No abstract available. PMID: 17368549 Similar articles Select item 1050907148.
Strongyloides stercoralis infection: how to diagnose best?
van der Feltz M, Slee PH, van Hees PA, Tersmette M.Neth J Med. 1999 Sep;55(3):128-31.PMID: 10509071 Similar articles Select item 2032941849.
Pulmonary strongyloidiasis.
Jayaprakash B, Sandhya S, Anithakumari K.J Assoc Physicians India. 2009 Jul;57:535-6.PMID: 20329418 Similar articlesSelect item 821239050.
[Systemic strongyloidiasis. Hyperinfection syndrome and disseminated strongyloidiasis].
Hagelskjaer LH.Ugeskr Laeger. 1993 Aug 30;155(35):2715-6. Danish. PMID: 8212390 Similar articles Select item 1581502351.
Comparison of the quantitative formalin ethyl acetate concentration technique and agar plate culture for diagnosis of human strongyloidiasis.
Intapan PM, Maleewong W, Wongsaroj T, Singthong S, Morakote N.J Clin Microbiol. 2005 Apr;43(4):1932-3.PMID: 15815023 Free PMC Article Similar articles Select item 1192223452.
Human strongyloidiasis in AIDS era: its zoonotic importance.
Singh S.J Assoc Physicians India. 2002 Mar;50:415-22. Review.PMID: 11922234 Similar articles Select item 2063748353.
Hình 2
Clinical and epidemiological features of 33 imported Strongyloides stercoralis infections.
González A, Gallo M, Valls ME, Muñoz J, Puyol L, Pinazo MJ, Mas J, Gascon J.
Trans R Soc Trop Med Hyg. 2010 Sep;104(9):613-6. doi: 10.1016/j.trstmh.2010.06.001. Epub 2010 Jul 16.
PMID: 20637483 Similar articles Select item 2329873154.
Evaluation of real-time PCR for Strongyloides stercoralis and hookworm as diagnostic tool in asymptomatic schoolchildren in Cambodia.
Schär F, Odermatt P, Khieu V, Panning M, Duong S, Muth S, Marti H, Kramme S.Acta Trop. 2013 May;126(2):89-92. doi: 10.1016/j.actatropica.2012.12.012. Epub 2013 Jan 5.PMID: 23298731 Similar articles Select item 1715369855.
New trends in diagnosis and treatment of chronic intestinal strongyloidiasis stercoralis in Egyptian patients.
Massoud AM, El-Shazly AM, Awad SE, Morsy AT, Sadek GS, Morsy TA.J Egypt Soc Parasitol. 2006 Dec;36(3):827-44.PMID: 17153698 Similar articles Select item 1546897656.
Pulmonary strongyloidiasis in a patient receiving prednisolone therapy.
Namisato S, Motomura K, Haranaga S, Hirata T, Toyama M, Shinzato T, Higa F, Saito A.Intern Med. 2004 Aug;43(8):731-6.PMID: 15468976 Free Article Similar articles Select item 967428057.
Cryo-microtome sections of coproculture larvae of Strongyloides stercoralis and Strongyloides ratti as antigen sources for the immunodiagnosis of human strongyloidiasis.
Costa-Cruz JM, Bullamah CB, Gonçalves-Pires Mdo R, Campos DM, Vieira MA.Rev Inst Med Trop Sao Paulo. 1997 Nov-Dec;39(6):313-7.PMID: 9674280 Similar articlesSelect item 1694913558.
Strongyloides stercoralis hyperinfection in systemic lupus erythematosus and the antiphospholipid syndrome.
Mora CS, Segami MI, Hidalgo JA.Semin Arthritis Rheum. 2006 Dec;36(3):135-43. Epub 2006 Sep 1. Review.PMID: 16949135 Similar articles Select item 1589517959.
[Purpura in patient with disseminated strongiloidiasis].
Ribeiro LC, Rodrigues Junior EN, Silva MD, Takiuchi A, Fontes CJ.Rev Soc Bras Med Trop. 2005 May-Jun;38(3):255-7. Epub 2005 May 4. Portuguese. PMID: 15895179 Free Article Similar articles Select item 1583982560.
[Strongyloides stercoralis hyperinfection in a patient with acquired immunodeficiency syndrome].
Sauca Subías G, Barrufet Barque P, Besa Beringues A, Rodríguez Ramos E.An Med Interna. 2005 Mar;22(3):139-41. Spanish. PMID: 15839825 Similar articles
Frequency of Strongyloides stercoralis infection in alcoholics.
de Oliveira LC, Ribeiro CT, Mendes Dde M, Oliveira TC, Costa-Cruz JM.Mem Inst Oswaldo Cruz. 2002 Jan;97(1):119-21.PMID: 11992161 Free Article Similar articles Select item 941918862.
Recombinant cDNA clones for immunodiagnosis of strongyloidiasis.
Ramachandran S, Thompson RW, Gam AA, Neva FA.J Infect Dis. 1998 Jan;177(1):196-203.PMID: 9419188 Similar articlesSelect item 1120090363.
Strongyloides hyperinfection syndrome--an unappreciated opportunistic infection.
Sekhar U, Madan M, Ranjitham M, Abraham G, Eapen G.J Assoc Physicians India. 2000 Oct;48(10):1017-9.PMID: 11200903 Similar articles Select item 2378997464.
Strongyloides stercoralis infection in an intestinal transplant recipient.
Hsu CN, Tseng SH, Chang SW, Chen Y.Transpl Infect Dis. 2013 Aug;15(4):E139-43. doi: 10.1111/tid.12104. Epub 2013 Jun 23.PMID: 23789974 Similar articles Select item 1898341665.

Hình 3
Strongyloides stercoralis hyperinfection syndrome after liver transplantation: case report and literature review.
Vilela EG, Clemente WT, Mira RR, Torres HO, Veloso LF, Fonseca LP, de Carvalho E Fonseca LR, Franca Md, Lima AS.Transpl Infect Dis. 2009 Apr;11(2):132-6. doi: 10.1111/j.1399-3062.2008.00350.x. Epub 2008 Oct 8. Review.PMID: 18983416 Similar articles Select item 1504275266.
[Strongyloidiasis im Moscow region].
Bronshteĭn AM, Malyshev NA, Milonova NG, Aliautdina LV.Med Parazitol (Mosk). 2004 Jan-Mar;(1):52-5. Russian. PMID: 15042752 Similar articles Select item 1624975267.
Stronglyoides stercoralis infection from pancreas allograft: case report.
Ben-Youssef R, Baron P, Edson F, Raghavan R, Okechukwu O.Transplantation. 2005 Oct 15;80(7):997-8. No abstract available. PMID: 16249752 Similar articles Select item 36212268.
Overwhelming strongyloidiasis: an unappreciated opportunistic infection.
Scowden EB, Schaffner W, Stone WJ.Medicine (Baltimore). 1978 Nov;57(6):527-44. Review.PMID: 362122 Similar articles Select item 749687469.
A case of systemic strongyloidiasis in an ex-coal miner with idiopathic colitis.
de Goede E, Martens M, Van Rooy S, VanMoerkerke I.Eur J Gastroenterol Hepatol. 1995 Aug;7(8):807-9.PMID: 7496874 Similar articles Select item 1919567170.
Molecular diagnosis of Strongyloides stercoralis in faecal samples using real-time PCR.
Verweij JJ, Canales M, Polman K, Ziem J, Brienen EA, Polderman AM, van Lieshout L.Trans R Soc Trop Med Hyg. 2009 Apr;103(4):342-6. doi: 10.1016/j.trstmh.2008.12.001. Epub 2009 Feb 4. Erratum in: Trans R Soc Trop Med Hyg. 2010 May;104(5):378. PMID: 19195671 Similar articles Select item 992126271.
Laboratory diagnosis of protozoan and parasitic infections. 2. Helminthiasis. j. Strongyloides stercoralis infection].
Iwamasa T.Rinsho Byori. 1998 Nov;Suppl 108:264-9. Review. Japanese. No abstract available. PMID: 9921262 Similar articles Select item 2308403072.

Hình 4
Strongyloidiasis in a high risk community of Dhaka, Bangladesh.
Sultana Y, Gilbert GL, Ahmed BN, Lee R.Trans R Soc Trop Med Hyg. 2012 Dec;106(12):756-62. doi: 10.1016/j.trstmh.2012.08.011. Epub 2012 Oct 22.PMID: 23084030 Similar articles Select item 268294873.
Global prevalence of strongyloidiasis: critical review with epidemiologic insights into the prevention of disseminated disease.
Genta RM.Rev Infect Dis. 1989 Sep-Oct;11(5):755-67. Review.PMID: 2682948 Similar articles Select item 977660674.
Endometrial strongyloides stercoralis in a healthy woman.
Vasei M, Kumar PV.Acta Obstet Gynecol Scand. 1998 Sep;77(8):871-2. No abstract available. PMID: 9776606 Similar articles Select item 367410075.
Strongyloides stercoralis hyperinfection in a patient with the acquired immune deficiency syndrome.
Maayan S, Wormser GP, Widerhorn J, Sy ER, Kim YH, Ernst JA.Am J Med. 1987 Nov;83(5):945-8.PMID: 3674100 Similar articles Select item 928955076.
[Infection by Strongyloides stercoralis in the county of Safor, Spain].
Cremades Romero MJ, Igual Adell R, Ricart Olmos C, Estellés Piera F, Pastor-Guzmán A, Menéndez Villanueva R.Med Clin (Barc). 1997 Jul 5;109(6):212-5. Spanish. PMID: 9289550 Similar articles Select item 2956789777.
Strongyloides stercoralis hyperinfection in an unconscious diabetic patient with dermatomyositis.
Sharifdini M, Hesari A, Mahdavi SA, Alipour A, Kia EB.Indian J Pathol Microbiol. 2018 Jan-Mar;61(1):109-112. doi: 10.4103/IJPM.IJPM_734_16.PMID: 29567897 Free Article Similar articles Select item 1950100878.

Hình 6
Secondary Strongyloides stercoralis prophylaxis in patients with human T-cell lymphotropic virus type 1 infection: report of two cases.
Peters L, McCarthy AE, Faught C.Int J Infect Dis. 2009 Nov;13(6):e501-3. doi: 10.1016/j.ijid.2009.02.009. Epub 2009 Jun 4.PMID: 19501008 Free Article Similar articles Select item 1523959979.
[Efficacy of ivermectin in the treatment of children parasitized by Strongyloides stercoralis].
Ordóñez LE, Angulo ES.Biomedica. 2004 Mar;24(1):33-41. Spanish. PMID: 15239599 Similar articles Select item 2741576480.
Strong-LAMP: A LAMP Assay for Strongyloides spp. Detection in Stool and Urine Samples. Towards the Diagnosis of Human Strongyloidiasis Starting from a Rodent Model.
Fernández-Soto P, Sánchez-Hernández A, Gandasegui J, Bajo Santos C, López-Abán J, Saugar JM, Rodríguez E, Vicente B, Muro A.PLoS Negl Trop Dis. 2016 Jul 14;10(7):e0004836. doi: 10.1371/journal.pntd.0004836. eCollection 2016 Jul.PMID: 27415764 Free PMC Article Similar articles
Comparison between PCR and larvae visualization methods for diagnosis of Strongyloides stercoralis out of endemic area: A proposed algorithm.
Repetto SA, Ruybal P, Solana ME, López C, Berini CA, Alba Soto CD, Cappa SM.Acta Trop. 2016 May;157:169-77. doi: 10.1016/j.actatropica.2016.02.004. Epub 2016 Feb 8.PMID: 26868702 Similar articles Select item 2173599482.
Strongyloidiasis: prevalence, risk factors, clinical and laboratory features among diarrhea patients in Ibadan Nigeria.
Dada-Adegbola HO, Oluwatoba OA, Bakare RA.Afr J Med Med Sci. 2010 Dec;39(4):285-92.PMID: 21735994 Similar articles Select item 2534321183.
Periumbilical purpura: challenge and answer. Diagnosis: Strongyloides stercoralis hyperinfection.
Osio A, Demongeot C, Battistella M, Lhuillier E, Zafrani L, Vignon-Pennamen MD.Am J Dermatopathol. 2014 Nov;36(11):899-900, 907. doi: 10.1097/DAD.0000000000000177. No abstract available. PMID: 25343211 Similar articles Select item 845933984.
Evaluation of three methods for laboratory diagnosis of Strongyloides stercoralis infection.
de Kaminsky RG.J Parasitol. 1993 Apr;79(2):277-80.PMID: 8459339 Similar articles Select item 807280985.

Hình 6
Fatal Strongyloides stercoralis hyperinfection diagnosed by Papanicolaou-stained sputum smears.
Sidoni A, Polidori GA, Alberti PF, Scionti L.Pathologica. 1994 Feb;86(1):87- 90.PMID: 8072809 Similar articles Select item 971522886.
Intestinal strongyloidiasis manifesting as eosinophilic pleural effusion.
Goyal SB.South Med J. 1998 Aug;91(8):768-9.PMID: 9715228 Similar articlesSelect item 2000311287.
Strongyloides stercoralis hyperinfection: difficulties in diagnosis and treatment.
Feely NM, Waghorn DJ, Dexter T, Gallen I, Chiodini P.Anaesthesia. 2010 Mar;65(3):298-301. doi: 10.1111/j.1365-2044.2009.06196.x. Epub 2009 Dec 10.PMID: 20003112 Free Article Similar articles Select item 1475590488.
[Strongyloides stercoralis in the south of Galicia].
Martínez-Vázquez C, González Mediero G, Núñez M, Pérez S, García-Fernaández JM, Gimena B.An Med Interna. 2003 Sep;20(9):477-9. Spanish. PMID: 14755904 Similar articles Select item 1629780989.
Fatal stongyloides hyperinfection in heart transplantation.
El Masry HZ, O'Donnell J.J Heart Lung Transplant. 2005 Nov;24(11):1980-3. Epub 2005 Aug 19.PMID: 16297809 Similar articles Select item 881760790.
Immunity to a challenge infection of Strongyloides stercoralis third-stage larvae in the jird.
Nolan TJ, Rotman HL, Bhopale VM, Schad GA, Abraham D.Parasite Immunol. 1995 Nov;17(11):599-604.PMID: 8817607 Similar articles Select item 789311091.
Intestinal ileus secondary to Strongyloides stercoralis infection: case report and review of the literature.
Bannon JP, Fater M, Solit R.Am Surg. 1995 Apr;61(4):377-80. Review.PMID: 7893110 Similar articles Select item 1752475892.
Maltreatment of Strongyloides infection: case series and worldwide physicians-in-training survey.
Boulware DR, Stauffer WM, Hendel-Paterson BR, Rocha JL, Seet RC, Summer AP, Nield LS, Supparatpinyo K, Chaiwarith R, Walker PF.Am J Med. 2007 Jun;120(6):545.e1-8.PMID: 17524758 Free PMC Article Similar articles Select item 766020993.
Corticosteroid-induced asthma: a manifestation of limited hyperinfection syndrome due to Strongyloides stercoralis.
Sen P, Gil C, Estrellas B, Middleton JR.South Med J. 1995 Sep;88(9):923-7.PMID: 7660209 Similar articles Select item 2134744794.
A coproantigen diagnostic test for Strongyloides infection.
Sykes AM, McCarthy JS.PLoS Negl Trop Dis. 2011 Feb 8;5(2):e955. doi: 10.1371/journal.pntd.0000955.PMID: 21347447 Free PMC ArticleSimilar articles Select item 1635824295.
Fatal Strongyloides stercoralis infection in a young woman with lupus glomerulonephritis.
Arsić-Arsenijević V, Dzamić A, Dzamić Z, Milobratović D, Tomić D.J Nephrol. 2005 Nov-Dec;18(6):787-90.PMID: 16358242 Similar articlesSelect item 2044473496.
Pancreatitis associated with Strongyloides stercoralis infection in a patient chronically treated with corticosteroids.
Jones N, Cocchiarella A, Faris K, Heard SO.J Intensive Care Med. 2010 May-Jun;25(3):172-4. doi: 10.1177/0885066609359992.PMID: 20444734 Similar articles Select item 2395591397.
[Strongyloides stercoralis hyperinfection syndrome in a patient with Behçet's Disease].
Yılmaz I, Cağlar B, Akay BN, Alkız G, Boyvat A, Akyol A.Turkiye Parazitol Derg. 2013;37(2):139-42. doi: 10.5152/tpd.2013.30. Turkish. PMID: 23955913 Free Article Similar articles Select item 2340920098.
Diagnosis, treatment and risk factors of Strongyloides stercoralis in schoolchildren in Cambodia.
Khieu V, Schär F, Marti H, Sayasone S, Duong S, Muth S, Odermatt P.PLoS Negl Trop Dis. 2013;7(2):e2035. doi: 10.1371/journal.pntd.0002035. Epub 2013 Feb 7.PMID: 23409200 Free PMC Article Similar articles. Select item 2342743899.
[Disseminated strongyloidosis in AIDS patients: apropos of two cases].
Dorvigny Scull Mdel C, Castro O, Angel Núñez F, Capó V.Rev Cubana Med Trop. 2006 May-Aug;58(2):165-8. Spanish. PMID: 23427438 Similar articles Select item 15633117100.
Image of the month. Strongyloides stercoralis hyperinfection and syndrome of inappropriate secretion of antidiuretic hormone.
Seet RC, Gong LL, Tambyath PA.Gastroenterology. 2005 Jan;128(1):8, 252. No abstract available. PMID: 15633117 Similar articles
Characterization of a recombinant immunodiagnostic antigen (NIE) from Strongyloides stercoralis L3-stage larvae.
Ravi V, Ramachandran S, Thompson RW, Andersen JF, Neva FA.Mol Biochem Parasitol. 2002 Nov-Dec;125(1-2):73-81.PMID: 12467975 Similar articlesSelect item 17852953102.
Parasitological and immunological diagnosis of Strongyloides stercoralis in patients with gastrointestinal cancer.
Machado ER, Teixeira EM, Gonçalves-Pires Mdo R, Loureiro ZM, Araújo RA, Costa-Cruz JM.Scand J Infect Dis. 2008;40(2):154-8.PMID: 17852953 Similar articlesSelect item 25877389103.
Comparative evaluation of Strongyloides ratti and S. stercoralis larval antigen for diagnosis of strongyloidiasis in an endemic area of opisthorchiasis.
Eamudomkarn C, Sithithaworn P, Sithithaworn J, Kaewkes S, Sripa B, Itoh M.Parasitol Res. 2015 Jul;114(7):2543-51. doi: 10.1007/s00436-015-4458-3. Epub 2015 Apr 17.PMID: 25877389 Similar articles Select item 19143887104.
Strongyloides stercoralis: a cause of morbidity and mortality for indigenous people in Central Australia.
Einsiedel L, Fernandes L.Intern Med J. 2008 Sep;38(9):697-703. doi: 10.1111/j.1445-5994.2008.01775.x.PMID: 19143887 Similar articles Select item 10756561105.
[A rare cause of asthma exacerbation: systemic anguilluliasis].
Rivals A, Rouquet RM, Recco P, Linas MD, Leophonte P, Didier A.Rev Mal Respir. 2000 Feb;17(1):99-102. French. PMID: 10756561 Similar articles Select item 12937738106.
Gastric strongyloidiasis and infection by the human T cell lymphotropic virus type 1 (HTLV-1).
Lambertucci JR, Leão FC, Barbosa AJ.Rev Soc Bras Med Trop. 2003 Jul-Aug;36(4):541-2. Epub 2003 Aug 13. No abstract available. PMID: 12937738 Free Article Similar articlesSelect item 23541119107.

Hình 8
The role of glycosylated epitopes in the serodiagnosis of Strongyloides stercoralis infection.
Inês Ede J, Silva ML, Souza JN, Teixeira MC, Soares NM.Diagn Microbiol Infect Dis. 2013 May;76(1):31-5. doi: 10.1016/j.diagmicrobio.2013.01.016. Epub 2013 Mar 27.PMID: 23541119 Similar articles Select item 25134190108.
Strongyloides hyperinfection syndrome complications: a case report and review of the literature.
Najmuddin A, Hadique S, Parker J.W V Med J. 2012 Jan-Feb;108(1):32-8. Review.PMID: 25134190 Similar articles Select item 8602647109.
Case report: strongyloidiasis refractory to treatment with ivermectin.
Ashraf M, Gue CL, Baddour LM.Am J Med Sci. 1996 Apr;311(4):178-9.PMID: 8602647 Similar articles Select item 14628954110.
High prevalence of Strongyloides stercoralis among farm workers on the Mediterranean coast of Spain: analysis of the predictive factors of infection in developed countries.
Román-Sánchez P, Pastor-Guzmán A, Moreno-Guillén S, Igual-Adell R, Suñer-Generoso S, Tornero-Estébanez C.Am J Trop Med Hyg. 2003 Sep;69(3):336-40.PMID: 14628954 Similar articlesSelect item 16883689111.
[Strongyloidosis. Part VII. Epidemiology and prevention (2)].
Soroczan W.Wiad Parazytol. 2000;46(3):345-64. Review. Polish. PMID: 16883689 Similar articlesSelect item 21896267112.
Efficacy of parasitological methods for the diagnosis of Strongyloides stercoralis and hookworm in faecal specimens.
Inês Ede J, Souza JN, Santos RC, Souza ES, Santos FL, Silva ML, Silva MP, Teixeira MC, Soares NM.Acta Trop. 2011 Dec;120(3):206-10. doi: 10.1016/j.actatropica.2011.08.010. Epub 2011 Aug 27.PMID: 21896267 Similar articlesSelect item 17605735113.
Strongyloides hyperinfection syndrome after intestinal transplantation.
Patel G, Arvelakis A, Sauter BV, Gondolesi GE, Caplivski D, Huprikar S.Transpl Infect Dis. 2008 Apr;10(2):137-41. Epub 2007 Jul 1.PMID: 17605735 Similar articles Select item 751221114.
Disseminated strongyloidiasis: report of seven cases.
Leelarasamee A, Nimmannit S, Na Nakorn S, Aswapokee N, Aswapokee P, Benjasuratwong Y.Southeast Asian J Trop Med Public Health. 1978 Dec;9(4):539-42.PMID: 751221 Similar articlesSelect item 23587590115.
[High risk of strongyloïdes hyperinfection in a patient with sarcoidosis].
Perez P, Debourgogne A, Valloton T, Nani A, Barraud H, Machouart M.Ann Biol Clin (Paris). 2013 Mar-Apr;71(2):211-4. doi: 10.1684/abc.2013.0809. French. PMID: 23587590 Free Article Similar articles Select item 22691685116.
Screening, prevention, and treatment for hyperinfection syndrome and disseminated infections caused by Strongyloides stercoralis.
Mejia R, Nutman TB.Curr Opin Infect Dis. 2012 Aug;25(4):458-63. doi: 10.1097/QCO.0b013e3283551dbd. Review.PMID: 22691685Free PMC Article Similar articles Select item 16888939117.
[Strongyloidosis. Part VIII. Parasitological diagnosis].
Soroczan W.Wiad Parazytol. 2002;48(2):155-71. Review. Polish. PMID: 16888939 Similar articles Select item 29059195118.
Strongyloides stercoralis is associated with significant morbidity in rural Cambodia, including stunting in children.
Forrer A, Khieu V, Schär F, Hattendorf J, Marti H, Neumayr A, Char MC, Hatz C, Muth S, Odermatt P.PLoS Negl Trop Dis. 2017 Oct 23;11(10):e0005685. doi: 10.1371/journal.pntd.0005685. eCollection 2017 Oct.PMID: 29059195 Free PMC Article Similar articles Select item 2201067119.
Opportunistic infections with Strongyloides stercoralis in renal transplantation.
DeVault GA Jr, King JW, Rohr MS, Landreneau MD, Brown ST 3rd, McDonald JC.Rev Infect Dis. 1990 Jul-Aug;12(4):653-71. Review.PMID: 2201067 Similar articlesSelect item 11345603120.
[Strongyloides stercoralis infestation in patients with chronic obstructive lung disease in Vega del Segura (Murcia). 3 case reports].
Pretel Serrano L, Page del Pozo MA, Ramos Guevara MR, Ramos Rincón JM, Martínez Toldos MC, Herrero Huerta F.Rev Clin Esp. 2001 Feb;201(2):109-10. Spanish. No abstract available. PMID: 11345603 Similar articles
Strongyloides stercoralis hyperinfection associated with human T cell lymphotropic virus type-1 infection in Peru.
Gotuzzo E, Terashima A, Alvarez H, Tello R, Infante R, Watts DM, Freedman DO.Am J Trop Med Hyg. 1999 Jan;60(1):146-9.PMID: 9988339 Similar articles Select item 25102174122.
Development of a rapid serological assay for the diagnosis of strongyloidiasis using a novel diffraction-based biosensor technology.
Pak BJ, Vasquez-Camargo F, Kalinichenko E, Chiodini PL, Nutman TB, Tanowitz HB, McAuliffe I, Wilkins P, Smith PT, Ward BJ, Libman MD, Ndao M.PLoS Negl Trop Dis. 2014 Aug 7;8(8):e3002. doi: 10.1371/journal.pntd.0003002. eCollection 2014 Aug.PMID: 25102174 Free PMC Article Similar articles Select item 15307419123.